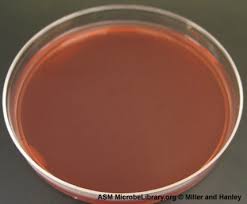
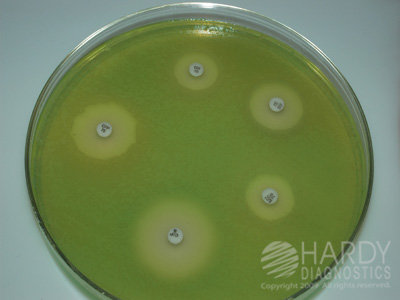
Mueler Hinton Agar
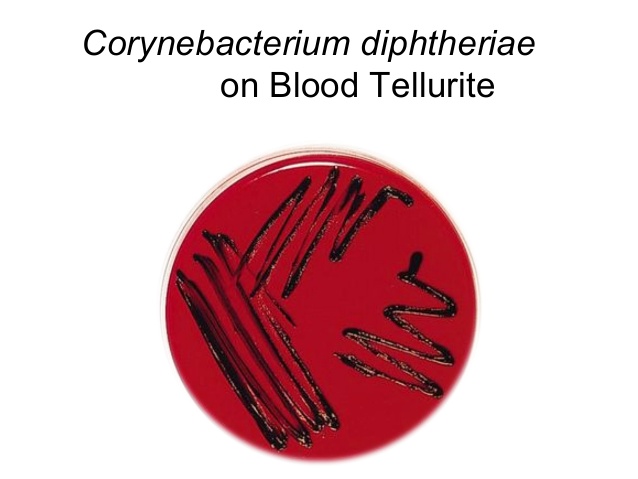
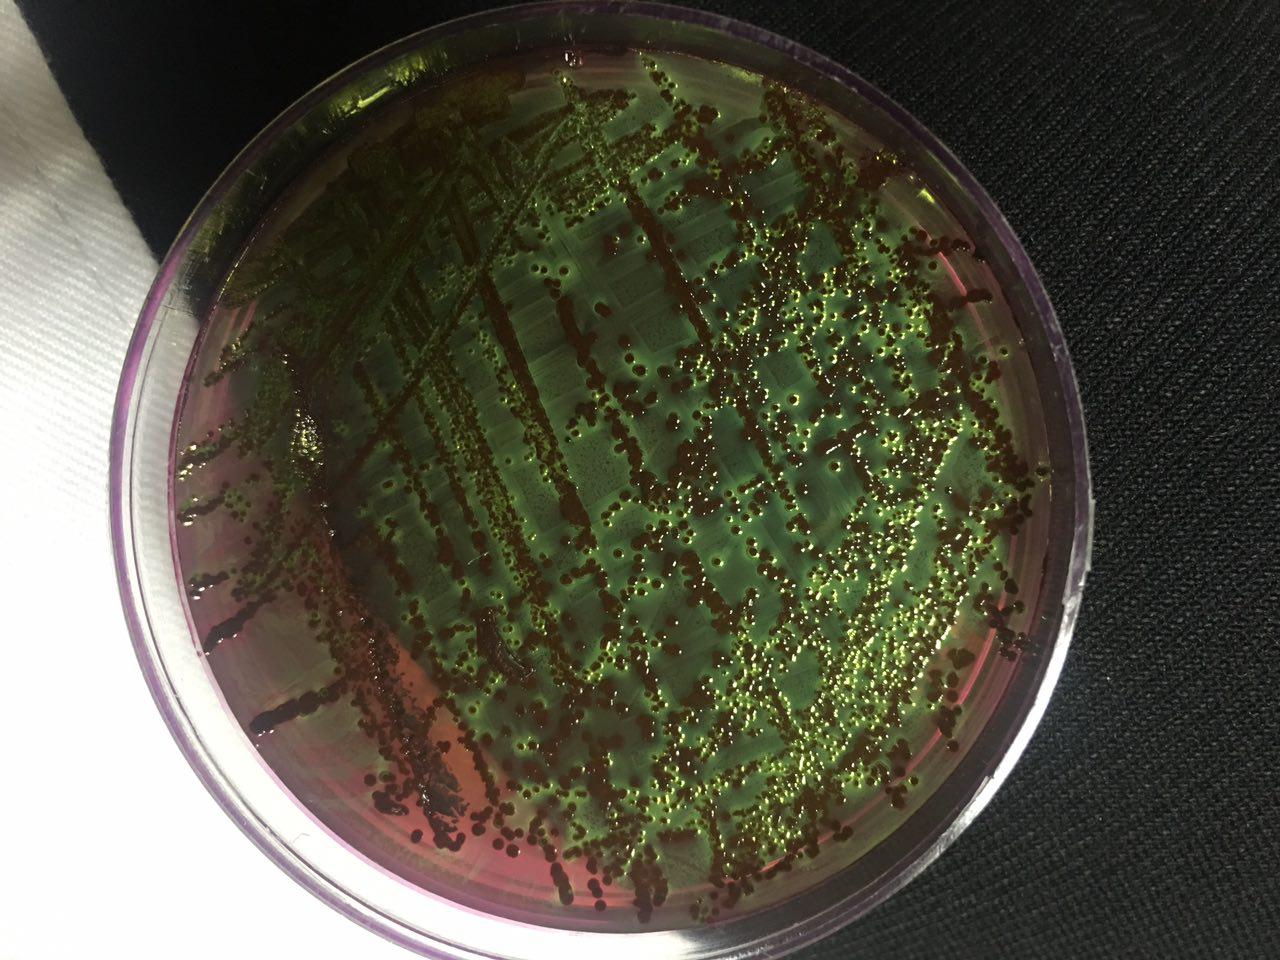
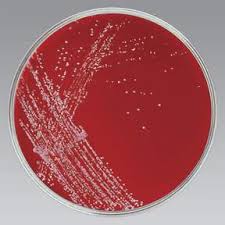

محیط کشت :
کشت سلولی (Cell Culture) فرآیندی است که طی آن سلول ها تحت شرایط کنترل شده غالبا خارج از محیط واقعی آنها رشد و تکثیر می یابند این شرایط میان سلول های مختلف متفاوت است که بر اساس نوع سلول باید شرایط ویژه آن اتخاذ شود.
محیط کشت (Culture Medium یا Growth Medium) :
یک محیط کشت جامد، مایع و یا نیمه جامد است که طراحی شده تا شرایط را برای رشد میکرو ارگانیسم ها ، سلول ها و یا گیاهان کوچک فراهم کند.
اکثرا از دو ماده ی آگار و ژلاتین می توان برای جامد کردن محیط کشت استفاده نمود اما به علت اینکه اولا محلول ژلاتین 15 درصد در دمای 24 درجه سانتی گراد ذوب می شود و دوما ژلاتین توسط اکثر باکتری های پروتئولیتیک(باکتری هایی مثل سودوموناس که با تولید پروتئاز خارج سلولی قادر به تجزیه پروتئین هستند) تجزیه می شود بیشتر از آگار برای جامد کردن محیط کشت استفاده می شود.
از آگار بیشتر برای محیط کشت های جامد و نیمه جامد باکترایی استفاده می شود و در واقع آگار از نظر غذایی چیزی به خواص غذایی محیط اضافه نمی کند بلکه فقط در دمای حدود 95 درجه سانتی گراد ذوب و در دمای حدود 42 درجه سانتی گراد به حالت جامد در می آید.
هر محیط کشت از اجزاء زیر تشکیل شده است :
1) منبع کربن (مثل گلوکز، گلوتامین) : به عنوان منبع انرژی
2) اسید آمینه : برای ساخت پروتئین
3) ویتامین : به رشد و بقای سلول کمک می کند
4) محلول با غلظت متعادل ( فشار اسمزی) : یک ترکیب متعادل از یون های مختلف برای تنظیم فشار اسمزی و همچنین شامل یون های فلزی برای کمک به فعالیت های آنزیمی
5) رنگ فنول رد : برای تشخیص حدود PH محیط رنگ فنول رد در PH 7 تا 4/7 از نارنجی به قرمز و در محیط اسیدی به رنگ زرد و در محیط های بازی به رنگ بنفش در می آید
6) محلول بافر : برای ثابت نگه داشتن PH محیط
انواع محیط کشت بر اساس ثبات :
1) محیط کشت جامد ( بین 5/1 تا 2 درصد آگار) :
برتری های محیط کشت جامد :
الف) می توان به وسیله ی مطالعه خصوصیات کلنی ها باکتری هارا شناسایی کرد.
ب) باکتری های مخلوط شده را می توان جداسازی کرد
2) محیط کشت مایع
3) محیط کشت نیمه جامد ( بین 5/0 تا 1 درصد آگار)
انواع پر کاربرد محیط کشت :
Nutrient Broth :
شامل 500 گرم گوشت برای مثال قلب گاو خورد شده و ترکیب شده با یک لیتر آب، 10 گرم پپتون ، 5 گرم سدیم کلرید و PH حدود 3/7 تنظیم می گردد.
موارد استفاده :
1) به عنوان یک محیط پایه برای تهیه سایر محیط کشت ها
2) برای مطالعه فرآورده های محلول باکتری ها

Nutrient Agar :
در دمای 37 درجه سانتی گراد جامد است و از اضافه کردن 5/1 تا 2 درصد آگار به محیط Nutrient Broth به دست می آید سپس تا دمای صد درجه سانتی گراد آنرا گرم می کنیم تا آگار ذوب شود و سپس آنرا سرد می کنیم.

Peptone Water :
از یک درصد پپتون و نیم درصد سدیم کلرید تشکیل شده است و به عنوان محیط کشت پایه برای محیط Sugar Medium و برای تست تشکیل ایندول (C8H7N) مورد استفاده قرار میگیرد.
Blood Agar :
بیشترین استفاده به عنوان محیط کشت را دارد از پنج تا ده درصد خون دفیبرینه شده (بدون فیبرین Defibrinated) اسب و یا گوسفند به آگار ذوب شده در دمای 45 درجه سانتی گراد تا 50 درجه سانتی گراد اضافه شده که به عنوان یک ماده غنی کننده و همچنین یک ماده شاخص به کار می رود. باکتری های رشد کرده در این محیط می توانند دارای سه نوع همولیز آلفا ( ناقص)، برخی بتا ( کامل) و برخی گاما ( فاقد همولیز ) باشد.

Heated Blood Agar یا Chocolate Agar :
با گرما دادن به Blood Agar بدست می آید و به عنوان محیط کشت باکتری های Gonococcusها ، Pneumococcus ها ، Haemophilus ها ، Meningococcus ها مورد استفاده قرار می گیرد.
گرما دادن به خون باعث غیر فعال شدن مهارکننده رشد و همچنین باعث پاره شدن گلبول های قرمز و پخش شدن مواد موجود در آنها در محیط کشت می شود.

Macconkey Agar :
بیشتر برای خانواده انتروباکتریاسه(enterobacteriaceae) که شامل آگار، پپتون، سدیم کلرید، نمک های صفراوی، لاکتوز، محلول بافر، کریستال ویوله و شناساگر قرمز خنثی (Neutral Red) می باشد.
این محیط کشت یک محیط کشت انتخابی و همچنین یک محیط کشت شاخص به حساب می آید.
1) محیط انتخابی: نمک های صفراوی جلوی رشد انتروباکتریاسه هارا نمی گیرند اما جلوی رشد بسیاری از انواع دیگری از باکتری هارا می گیرد.
2) محیط شاخص(تشخیص دهنده) : در طی تخمیر لاکتوز توسط کلنی های باکتریایی اسید تولید شده و این اسید باعث تولید رنگ صورتی توسط قرمز خنثی می شود. به این نوع باکتری ها مثل اشرشیا کولای (Escherichia colli )باکتری های تخمیر کننده لاکتوز گویند. کلنی های بی رنگ آن نشان دهنده تخمیر نشدن لاکتوز هستند به عنوان مثال سالمونلا، شیگلا و ویبریو توانایی تخمیر لاکتوز را ندارند.

Mueler Hinton Agar :
برای بررسی حساسیت باکتری ها به دارو های ضد میکروبی (آنتی بیوگرام) مورد استفاده قرار میگیرد. این دارو ها بصورت دیسک هایی روی محیط کشت قرار گرفته و از روی داشتن و یا نداشتن حاله ی عدم رشد و قطر حاله می توان تاثیر این دارو هارا بر روی باکتری مورد نظر مورد ارزیابی قرار داد.

Hiss`s Serum Water Medium :
این محیط کشت برای مطالعه ی واکنش های تخمیری باکتری هایی که نمی توانند روی محیط کشت Peptone Water Sugar رشد کنند مثل Pneunacoccus، Neisseria، Corynebacteriun
Lowenstein-jensen Medium :
این محیط کشت برای رشد توبرکول باسیلی ( Tubercle bacilli) به کار می رود شامل تخم مرغ، مالاکیت سبز(Malachite green) و گلیسرول می شود.
تخم مرغ یک ماده غنی کننده است که رشد توبرکول باسیلی را تحریک می کند.
مالاکیت سبز از رشد سایر ارگانیسم ها به جز مایکوباکتری ها (Mycobacteria) جلوگیری می کند.
گلیسرول رشد مایکوباکتریمو توبرکلوزیس(Mycobacterium tuborculosis ) را ترویج داده اما جلوی رشد مایکوباکتریوم بوویس ( Mycobacteruim bovis ) را میگیرد.

Dubos Medium:
این محیط مایع برای توبرکول باسیلی مناسب است. در این محیط حساسیت توبرکول باسیلی نسبت به داروها می تواند مورد مطالعه قرار گیرد. این محیط شامل Tween 80، سرم گاوی، آلبومن، کازئین هیدروزیلات، آسپاراژین و انواع نمک ها می شود. Tween 80 باعث رشد پراکنده و آلبومن گاوی باعث رشد سریع می شود.
Loeffler Serum :
این سرم برای غنی کردن استفاده می شود. دیفتریا باسیلی (Diphtheria bacilli) می تواند در شش ساعت رشد کند در حالی که جلوی رشد باکتری های فرعی را می گیرد. این میط کشت برای تشخیص سریع دیفتری و برای نشان دادن گرانول های مارپیچی آن استفاده می شود. این محی شامل سرم اسب، گاو نر و یا گوسفند است.

Tellurite Blood Agar:
این محیط به عنوان محیط انتخابی برای کوتینو باکتریوم دیفتریا (Cotynebacterium diphtheriae) استفاده می شود.
تلوریت مانع رشد بیشتر باکتری های فرعی بدون تاثیر بر روی رشد دیفتریا باسیلی(Diphtheria bacilli) می شود و همچنین این محیط یک محیط شاخص محسوب می شود که باکتری دیفتریا باسیلی در این محیط کلنی های مشکی رنگ تولید می کند. تلوریت به تلبریسم (tellberism) مشکی رنگ متابولیز می شود.

(EMB Agar(Eosin-methylen blue :
یک محیط کشت انتخابی و افتراقی برای باکتری های میله ای و گرم منفی روده است که مانع رشد اکثر باکتری های گرم مثبت میشود. این محیط شامل دو نوع رنگ شاخص ائوزین و متیلن بلو است که بهعث می شود که کلنی های تخمیر کننده ی لاکتوز رنگی شده و کلنی هایی که لاکتوز را تخمیر نمی کنند بصورت بی رنگ ظاهر می شوند. باکتری E-coli در این محیط جلای سبز فلزی خواهد داشت.

(XLD (Xylose lysine deoxychorate :
براي جدا كردن كونه هاي سالمونلا (Salmonella) و شيگلا (Shigella) از نمونه ي مدفوع استفاده می شود. اين محيط يك محيط انتخابي است و دارای ترکیبات پپتون، لاکتوز، سیترات سدیم، سیترات فریک، کلرو سدیم، فسفات دی پتاسیک، دی اکسی کلات سدیم، آگار، قرمز خنثی و آب مقطر است. PH محیط حدود 2/7 است.

(SS Agar (Salmonella-Shigella:
اين يك محيط انتخابي دارای ترکیبات پپتون، لاکتوز، املاح صفراوی، قرمز خنثی (Neutral Red)، آگار، بریلین گرین و تیوسولفات سدیم است و براي جدا كردن گونه هاي سالمونلا (Salmonella ) و شيگلا( Shigella) مورد استفاده قرار ميگيرد. بریلین گرین موجود در این محیط از رشد سایر باکتری های گرم مثبت و دیگر گرم منفی ها جلوگیری می کند. و توانایی تشخیص باکتری های تخمیر کننده لاکتوز از باکتری های فاقد این توانایی را دارد باکتری های سالمونلا و شیگلا قادر به تخمیر لاکتوز نبوده و ایجاد کلنی های بیرنگ می کنند که ارزش تشخیصی دارد.SSAgar با نمك صفراوي اضافي وقتي مورد استفاده قرار ميگيرد که به Yersinia enterocolitica مشكوك باشیم.

(DCA (Desoxycholate citrate Agar
براي جداكردن سالمونلا و شيگلا بكار ميرود. بقيه باكتري هاي داخلي روزه معمولا توانايي رشد در اين محيط را ندارند. (محيط كشت انتخابي) اين محيط همچنين يك محيط شاخص است به علت حضور لاكتوز و قرمز خنثي
Tetrathionate Broth :
اين محيط براي پيدا كردن سالمونلا از مدفوع مورد استفاده قرار ميگيرد پس به عنوان يك محيط انتخابي عمل ميكند. اين محيط مانع رشد باكتري هاي معمولي ( باکتری های گرم مثبت و بسیاری از گرم منفی ها) داخل روده ميشود و اجازه تكثير سالمونلا را مي دهد.
Selenite f broth :
مورد استفاده و عملكرد ان مانند Tetrathionate broth است.

(TCBS (Thiosulphute-Citrate-Bile-Sucrose:
اين محيط يك محيط كشت انتخابي براي پيدا كردنVibrio cholerae و بقيه گونه هاي vibrio از مدفوع است. این محیط کشت به علت دارا بودن غلظت بالای تیوسولفات و سیترات و قلیایی بودن رشد آنتروباکتریاسه هارا تا حد زیادی متوقف می کند باکتری هایی که در این محیط رشد می کنند غالبا قادر به متابولیز ساکارز نمی باشند.

Charcoal-yeast Agar:
براي legionella Dneumaphila مورد استفاده قرار ميگيرد. تمركز زياد بر روي اهن و سيستئين اجازه رشد ميدهد.

Campylobacter medium:
اين محيط انتخابي براي جدا كردن compylobacter jejuni و campylobacter از مدفوع استفاده ميشود.

(TGAM (tellurite-Gelatin Agar Medium :
می تواند به عنوان یک محیط انتقالی، انتخابی و شاخص مورد استفاده قرار گیرد.
Cary-Blair Medium :
این محیط یک محیط انتقالی برای نمونه های مدفوع مشکوک به گونه های سالمونلا و شیگلا و ویریو و Campylobacter به کار می رود.
Amies Medium :
برای Yonococci و سایر پاتوژن های به کار می رود.
Peptone Water sugar Medium :
این محیط کشت شاخص برای مطالعه ی تخمیر قند ها مورد استفاده قرار می گیرد یک درصد قند ( لاکتوز، گلوکز، مانیتول و ...) به محلول پپتون حاوی شناساگر آندراد ( Andrade`s indicator) داخل لوله آزمایش اضافه می شود. یک لوله کوچک دراهام بصورت برعکس در این محیط بی رنگ قرار می گیرد و پس از رشد باکتری تغییر رنگ محیط به رنگ قرمز حاکی از سنتز اسید است و درصورت تولید گاز این گاز در لوله دراهام جمع آوری می شود و قابل مشاهده است.
(MIU (Motility Indole Urea Medium :
برای جداسازی گونه های مختلف انتروباکتری ها (Entrobacteria )مورد استفاده قرار می گیرد برای جداسازی این گونه ها از تحرک، آنزیم اوره آز و تولید ایندول (C8H7N) استفاده می شود.
(TSI(Triple Sugar Iron Agar :
در تشکیل این محی کشت از سه قند گلوکز، لاکتوز، ساکارز، پپتون، تیوسولفات، آهن، آگار، محلول بافر و معرف استفاده شده است این محیط به علت دارا بودن دو بخش سطحی و عمقی در لوله می تواند نشان دهنده تخمیر قند ها و تولید H2S و CO2 باشد. در صورت استفاده گر بودن باکتری لوله آزمایش اسیدی و زرد رنگ و در غیر اینصورت لوله تماما قلیایی و قرمز رنگ دیده می شود اسیدی بودن را با حرف A و قلیایی شدن را با (K (ALK نشان می دهیم
نتایج ممکن برای آزمایش :
A/A : محیط کاملا اسیدی و زرد رنگ است و تمام قند ها توسط باکتری مصرف شده است.
K/A : در این حالت طی 72 ساعت فقط گلوکز مصرف شده و بقیه قند ها دست نخورده باقی مانده اند.
K/K : هیچ قندی مصرف نشده و محیط قلیایی و قرمز رنگ باقی مانده است.
در طی این آزمایش در صورتی که باکتری از تیوسولفات سدیم استفاده کرده باشد به علت تولید H2S قسمت سیاه رنگی در پایین لوله آزمایش مشاهده می شود و همچنین اگر بر اثر تخمیر باکتری CO2 تولید شده باشد شاهد ایجاد حباب، ترک خوردن یا حرکت محیط کشت به سمت بالا را مشاهده می کنیم.

(KIA (Kligler iron agar :
یک محیط کشت شیب دار، تشخیص دهنده برای تشخیص باکتری های روده ای (Entric bacteria) مورد استفاده قرار میگیرد واکنش ها بر اساس تخمیر لاکتوز و گلوکز و تولید هیدروژن سولفید هستند.

Christensen`s Urea Medium:
این محیط برای تشخیص ارگانیسم های تجزیه کننده اوره برای مثال پروتئوس (proteus) به کار می رود به وجود آمدن رنگ صورتی بنفش نشان دهنده تجزیه اوره است.

Bordet-Gengou Medium :
از این محیط برای رشد و تکثیر Bordetella pertussis مورد استفاده قرار می گیرد. تمرکز زیاد بر روی خون اجازه رشد را به باکتری می دهد شامل آگار، سیب زمینی، سدیم کلرید، گلیسرول، پپتون و پنجاه درصد خون اسب می شود امکان اضافه کردن پنی سیلین نیز به آن وجود دارد.

(MR-VP(Methylred-Vegesproskaure broth :
این محیط بطور کلی در تفکیک و تشخیص کلیه فرم ها بویژه برای تفکیک مسیر های تخمیر گلوکز و در نهایت ایجاد ترکیبات اسید آلی بوتان دی ال یا بوتیلن گلایکل و همچنین تمایز بین استافیلوکوک و میکرو کوک و گونه ها ی آنها کاربرد دارد.
معرف MR : ( متیل رد اتانول آب مقطر )
نتیجه : ظهور رنگ قرمز : آزمایش مثبت ( PH=4/4)
ظهور رنگ نارنجی : آزمایش مثبت ضعیف ( PH=5/3)
ظهور رنگ زرد : آزمایش منفی ( PH=5/3)
معرف A در VP : ( آلفانفتول الکل اتلیک مطلق)
معرف B در VP : (هیدروکسید پتاسیم آب مقطر)
نتیجه : ظهور رنگ صورتی تا قرمز : مثبت
بدون تغییر رنگ : منفی

این وبلاگ رو من و دوستان عزیزم برای افزایش اطلاعات خودمون و شما بازدیدکنندگان و دوستان عزیز ایجاد کردیم
این وبلاگ رو من و دوستان عزیزم برای افزایش اطلاعات خودمون و شما بازدیدکنندگان و دوستان عزیز ایجاد کردیم